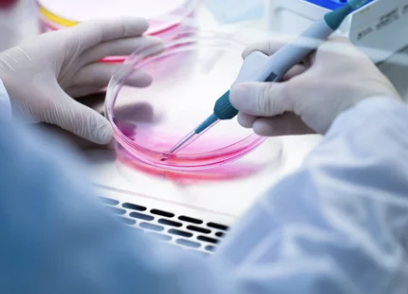

줄기세포 주사 가격 알아보기
- 건강에 대한 흥미로운 정보들
- 2026. 2. 3. 18:53
치료 유형별 · 부위별 · 비용 비교 완전정리
최근 건강·재활·미용 분야에서
줄기세포 주사 치료에 대한 관심이 커지고 있습니다.
통증 완화, 관절 기능 개선, 피부 재생 등
다양한 분야에서 활용되기 때문입니다.
하지만 줄기세포 주사는
✔ 시술 목적
✔ 사용되는 세포 종류
✔ 병원·클리닉
에 따라 비용 차이가 매우 큽니다.
이번 글에서는
줄기세포 주사 치료의 가격 범위와 유형별 특징을
쉽고 빠르게 비교해드립니다.
1. 줄기세포 주사란?



줄기세포 주사는
신체 조직의 재생 능력을 활성화하기 위해
줄기세포 또는 줄기세포 유래 성분을 주입하는 치료입니다.
✔ 관절·연골 치료
✔ 근골격계 통증 완화
✔ 미용·피부 재생
✔ 탈모 개선
등 다양한 목적에 활용되며,
비용은 치료 목적과 치료 부위에 따라 달라집니다.
2. 줄기세포 주사 치료 유형
줄기세포 치료는 크게 두 가지 유형으로 나뉩니다.
✔ 자가 줄기세포 치료
본인 지방·골수에서 추출하여
처리 후 주입하는 방식입니다.
✔ 치료 효과에 대한 만족도가 높음
✔ 면역반응 위험 낮음
✔ 비용은 다소 높음
✔ 동종 줄기세포 치료
타인의 줄기세포를 활용하는 방식입니다.
✔ 시술 간편
✔ 대량 생산이 가능
✔ 비용이 비교적 다양
3. 줄기세포 주사 가격 비교



줄기세포 주사 가격은
치료 목적, 사용 세포 종류, 병원 등에 따라 크게 다르지만,
아래는 대표적인 치료 유형별 대략적인 가격 가이드입니다.
치료 목적치료 부위대략 가격대
| 관절·연골 재생 | 무릎/어깨 등 | 150만 ~ 500만 원 |
| 근골격계 통증 완화 | 허리/목/근육 | 100만 ~ 400만 원 |
| 미용·피부 재생 | 얼굴/목 | 100만 ~ 300만 원 |
| 탈모 개선 | 두피 | 200만 ~ 600만 원 |
| 자가 줄기세포 추출 + 주입 | 다양한 부위 | 300만 ~ 1000만 원 이상 |
※ 실제 비용은 병·의원 또는 클리닉의
진단 결과, 치료 횟수, 세포 처리 방식에 따라 달라질 수 있습니다.
4. 줄기세포 주사, 치료 횟수에 따라 달라지는 비용
줄기세포 주사는
한 번만 시행하는 경우도 있지만,
여러 차례 반복 시술이 필요한 경우가 많습니다.
✔ 1회 시술
✔ 2~3회 집중 치료
✔ 장기 추적 치료
횟수가 늘어날수록
총 비용은 상승합니다.
5. 줄기세포 주사와 건강보험



줄기세포 주사 치료는
대부분 건강보험 적용이 되지 않는 비급여 치료입니다.
✔ 전액 본인 부담
✔ 의료기관마다 가격 다양
✔ 적정 비용·효과 비교 중요
따라서
비용 부담이 클 수 있기 때문에
시술 전 정확한 상담과 비용 견적 확인이 필요합니다.
6. 꼭 알고 있어야 할 가격 확인 팁
✔ 시술 목적과 부위 확정 후 상담
✔ 치료 횟수와 회차별 비용 확인
✔ 포함 항목(진단, 주사, 추적 검사) 체크
✔ 치료 전·후 관리 비용 확인
동일한 치료 목적이라도
병원마다 가격 구성과 포함 항목이 다르기 때문에
명확히 비교해보는 것이 중요합니다.
7. 부작용·안전성 고려하기

줄기세포 주사는 비교적 안전한 치료로 알려졌지만,
사용되는 세포 종류나 시술 방식에 따라
개인별 반응 차이가 있을 수 있습니다.
✔ 시술 전 전문 상담
✔ 추적 관찰 계획 수립
✔ 이상 반응 발생 시 즉시 의료진 상담
“가격”뿐 아니라
“안전성과 효과”를 함께 고려해야 합니다.
마무리
줄기세포 주사 치료는
✔ 통증 완화
✔ 기능 개선
✔ 피부 재생
같은 다양한 분야에서 활용되며
맞춤형 치료 옵션으로 선택되는 경우가 많습니다.
하지만
비용이 비급여이기 때문에
✔ 치료 목적
✔ 횟수
✔ 병원별 가격
✔ 포함 항목
을 꼼꼼히 비교하고
비용 대비 효과를 고려해 선택하는 것이
가장 현명한 접근입니다.
줄기세포 주사를 고려 중이라면
사전에 충분한 상담을 통해
자신에게 맞는 치료 계획과 비용 구성을 확인해 보세요.